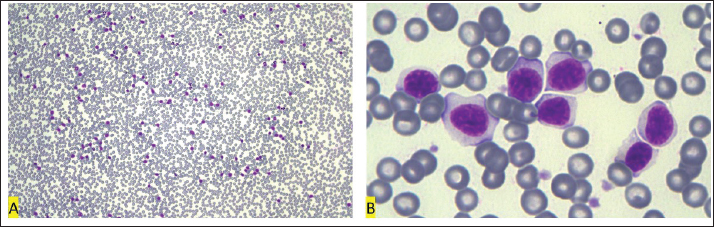
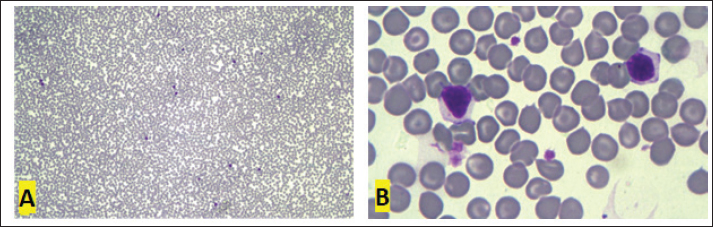

| Case Report | ||
Open Vet. J.. 2023; 13(12): 1760-1768 Open Veterinary Journal, (2023), Vol. 13(12): 1760–1768 Case Report Extreme lymphocytosis in a dog with T-zone lymphomaBruna Voltolin de Sena1, Bárbara Correa de Mello1, Rodrigo dos Santos Horta1, Mariana de Pádua Costa1, Marilia Martins Melo1, Reysla Maria da Silveira Mariano2, Rodolfo Cordeiro Giunchetti2, Antonio Giuliano3*, Fabiola de Oliveira Paes Leme1, Adriano de Paula Sabino4, and Paulo Ricardo de Oliveira Paes11Departament of Veterinary Medicine and Surgery, Veterinary School, Universidade Federal de Minas Gerais, Belo Horizonte, Minas Gerais, Brazil 2Department of Morphology, Institute of Biological Sciences, Universidade Federal de Minas Gerais, Belo Horizonte, Minas Gerais, Brazil 3Departament of Veterinary Clinical Science, Jockey Club College of Veterinary Medicine, City University of Hong Kong, Hong Kong 4Department of Clinical and Toxicological Analysis, Faculty of Pharmacy, Universidade Federal de Minas Gerais, Belo Horizonte, Minas Gerais, Brazil *Corresponding Author: Antonio Giuliano. Department of Veterinary Clinical Science, Jockey Club College of Veterinary Medicine, City University of Hong Kong, Hong Kong. Email: agiulian [at] cityu.edu.hk Submitted: 15/09/2023 Accepted: 29/11/2023 Published: 31/12/2023 © 2023 Open Veterinary Journal
AbstractBackground: Canine T-zone lymphoma (TZL) is recognized as an indolent CD45-T cell lymphoma, with low aggressiveness and high overall survival. The diagnosis is obtained by histopathology and immunohistochemistry, but also by cytological examination of the lymph node associated with immunophenotyping. Lymphocytosis is commonly identified as around 10,000 cells/µl and may reach 30,760 cells/µl. Case Description: The present report describes a case of a female Golden Retriever, nine years old, with generalized lymphadenopathy. In the cytological examination of the superficial cervical lymph node, a monomorphic population of small, “clear cells” and “hand mirror” lymphocyte shape was suggestive of TZL. The leukogram showed intense leukocytosis (160,050 cells/μl) due to small clear cell lymphocytosis (152,048 cells/μl). The myelogram showed a myeloid:erythroid ratio of 2:3; with a pyramidal distribution of cell types and the presence of 22.8% of lymphocytes in the differential count. Bone marrow, peripheral blood, and lymph node immunophenotyping resulted in lymphocyte gates with 97.3% to 99.5% CD5+, predominantly CD4-, CD8-, and CD45- confirming the diagnosis of TZL with associated leukemia. Treatment with chlorambucil and prednisolone was started. During the first month, the lymphocytosis remained above 200,000 cells/uL. After four months of treatment, there was a decrease in lymphocytes, which progressively reached a count of 10,800 cells/ul in the eleventh month. Conclusion: In the literature, lymphocytosis above 30,760 cells/μl has not been observed in TZLs. Thus, it is believed that this is the first report of extreme lymphocytosis with a slow response to chemotherapy. Keywords: Cytology, Flow cytometry, Immunophenotyping, Indolent lymphoma, Lymphocytosis. IntroductionCanine T-zone lymphoma (TZL) comprises 30%–40% of low-grade lymphomas in dogs with an average age onset of 9 years (Seelig et al., 2014). The Golden Retriever stands out with a high prevalence, particularly in certain regions, including Brazil (Jark et al., 2020). TZL exhibits an indolent nature with slow progression and long survival. Typically, it involves one or more lymph nodes, but it has also been reported in other tissues such as the skin and tongue. Peripheral blood involvement may occur with or without lymphocytosis, which is not associated with a worse prognosis. Lymphocytosis is commonly observed at around 10,000 cells/µl and may reach 30,760 cells/µl (Martini et al., 2015). Diagnosis is achieved through histopathology and immunohistochemistry, as well as cytological examination of the lymph node, accompanied by immunophenotyping with loss of CD45 expression. Despite its indolent nature, achieving complete remission can be challenging even with chemotherapy treatment (Mizutani et al., 2016). Case DetailsA nine-year-old female Golden Retriever, weighing 34.2 kg, was attended at the Veterinary Hospital of the Universidade Federal de Minas Gerais (UFMG, Brazil), for investigation of a 3 cm lump in the inguinal mammary gland. On physical examination, there was generalized lymphadenopathy and a body score of 7/9, with remaining physical parameters within normal limits. An abdominal ultrasound was performed, revealing hepatomegaly with the presence of a nodule, iso-to-slightly hypoechoic and homogeneous, measuring approximately 6.22 × 4.26 cm; discrete splenomegaly with heterogenous appearance due to small nodular hypoechoic lesions with diameters varying between 0.32 and 0.62 enlarged medial iliac lymph nodes (left measuring 1.63 × 3.87 cm, right measuring 2.29 × 3.81 cm). Fine needle aspiration of the spleen, liver, superficial cervical lymph node, bone marrow, and peripheral blood were performed. The cytology of the lymph node showed an amorphous basophilic material and a moderate concentration of fat vacuoles and red blood cells (Fig. 1A and B). Nucleated cells were presented in intense concentration, composed of lymphoid cells (97%), macrophages (2%), and neutrophils (1%). Among lymphoid cells, 85% were classified as small, 10% as medium, and 5% as large, with the small cells often having clear, unipolar cytoplasm, typical of “clear cells” and “hand mirror” shapes. The mitotic index was considered low, with only one mitotic figure in five fields at 400× magnification. In conclusion, the cytological examination was suggestive of TZL, and immunophenotyping was recommended for diagnostic confirmation and to rule out possible intense paracortical hyperplasia. In the first blood count, hematocrit was observed at the lower reference limit (37%), platelet counts slightly above the upper reference limit (551,000 cells/μl), and leukocyte counts far above the upper reference limit (160,050 cells/μl), with extreme lymphocytosis (152,048 cells/μl), mild eosinophilia (3,201 cells/μl), monocytopenia (0 cells/μl), and segmented neutrophil count within the normal range (4,801 cells/μl) (Jain, 1993) (Table 2). In the morphological evaluation, the peripheral lymphoid cells were classified as small to intermediate, with a decreased nucleus:cytoplasm ratio compared to typical small lymphocytes, and presenting round to oval nuclei with finely granular chromatin and slightly basophilic cytoplasm, with cell borders showing more intense basophilia, compatible with “clear cells” (Fig. 2A and B). In splenic cytology, a predominance of lymphocytes was observed with a morphological pattern similar to that observed in peripheral blood (Fig. 3A and B). In liver cytology, an intense concentration of hepatocytes was observed, with a slight cytoplasmic rarefaction (Fig. 4A and B), suggestive of hepatic nodular hyperplasia or well-differentiated neoplasia. Bone marrow aspiration was performed in the greater tuberosity of the humerus. The myelogram showed a low concentration of particles with a cellularity (cell:fat ratio) of 60% and a mean concentration of seven to eight megakaryocytes/spicule (Fig. 5A). The differentiation of cell types in the region around the particles (Fig. 5B) resulted in a myeloid: erythroid ratio of 2:3; with a pyramidal distribution of the myeloid lineage (myeloblasts: 1.8%; promyelocytes: 5.0%; myelocyte neutrophils: 11.4%; metamyelocyte neutrophils: 10.9%; rod neutrophils: 14.9% and segmented neutrophils: 8.4%; no eosinophilic or basophilic cells were observed) and erythroid (rubriblast: 1.1%; prorubrocyte: 2.0%; rubrocyte: 9.6%; and metarubrocyte: 10.4%). Lymphocytes (22.8%), plasma cells (1.4%), and monocytes (0.7%) were also observed. Lymphocytes were considered small and typical. With the suspicion of TZL/leukemia, immunophenotyping by flow cytometry of blood, lymph node, and bone marrow samples was performed in two different laboratories due to the availability of antibodies. In the Cytometry Laboratory of the Institute of Biological Sciences at UFMG, the markers CD5, CD4, CD8, CD14, and CD21 were analyzed, using four polystyrene tubes (Becton-Dickinson, USA) for each of the samples. In the first tube, the anti-canine antibodies CD5-FITC/CD4-PE were transferred together with the sample; in tube 2, the anti-canine antibodies CD5-FITC/CD8-PE; and in tube 3, the anti-human antibodies CD14-AlexaFluor 647 and CD21-PE. Samples were incubated for 30 minutes at room temperature and protected from light. In the fourth tube, no antibody was added as a negative control. The FACSCanthoII™-BD flow cytometer was used for data acquisition, with the DIVA software (Data-Interpolating Variational Analysis). FlowJo software (Flow Cytometry Analysis Software, version 7.6.1) was used for data analysis. The CD34 and CD45 markers were analyzed at the Institutional Laboratory for Biomarkers Research (https://www.farmacia.ufmg.br/linbio-ufmg/), Clinical and Toxicological Analysis Department of the UFMG College of Pharmacy, using three tubes (Becton-Dickinson, USA) for each sample. The cellular solution was incubated with anti-human CD45-eFluor and CD34-PE antibodies for 30 minutes at room temperature and protected from light in two of the tubes. The third tube was used as a negative control. Data acquisition and analysis were performed using the LSR Fortessa–Becton flow cytometer and FlowJo software (Flow Cytometry Analysis Software, version 7.6.1).
Fig. 1. Cervical lymph node cytology, Golden Retriever, T-zone lymphoma. (A) Predominance of small lymphoid cells, often in the shape of a “hand mirror.” 10x objective. (B) The “clear cells” have clear and unipolar cytoplasm, in the shape of a “hand mirror.” 40x objective. Diff-Quik staining. Table 1. Flow cytometry immunophenotyping results from the lymphocyte gate in blood, lymph node, and bone marrow samples from a Golden Retriever dog with T-zone lymphoma.
Table 2. Blood tests performed to monitor a Golden Retriever patient diagnosed with T-zone lymphoma.
Fig. 2. First blood smear, Golden Retriever, T-zone lymphoma. (A) Low red blood cell:white blood cell ratio (37:1) due to intense leukocytosis (5,940,000 RBCs/μl and 160,050 WBCs/μl). 10x objective. (B) “Clear cells” are small to intermediate and have clear and more abundant cytoplasm than typical lymphocytes. 100× objective. Diff-Quik staining.
Fig. 3. Splenic cytology, Golden Retriever, T-zone lymphoma. (A) Predominance of small lymphocytes. 40× objective. (B) Small lymphocytes are similar to those seen in peripheral blood. 100× objective. Diff-Quik staining.
Fig. 4. Liver cytology, Golden Retriever, T-zone lymphoma. (A) Predominance of hepatocytes in clusters of varying sizes. 10× objective. (B) Hepatocytes show cytoplasmic rarefaction. 40× objective. Diff-Quik staining.
Fig. 5. Myelogram, Golden Retriever, T-zone lymphoma. (A) Bone marrow particle. In this sample, the cell:fat ratio was estimated at 60%. 4× objective. (B) In the region around the particles, a concentration of 22.8% of typical small lymphocytes was observed. 40× objective. Diff-Quik staining. In peripheral blood immunophenotyping, the lymphocyte gate, which represented 80.9% of the nucleated cellularity, resulted in a CD5+phenotype in almost 100% of cells (Fig. 6.1). However, only 2.5% and 2.2% of these cells were CD4+ and CD8+, respectively. In addition to this atypia, 69.7% of cells were CD45-. Similar results were observed in lymph nodes and bone marrow immunophenotyping (Fig. 6.2 and 6.3). These results are summarized in Table 1. Based on the cytological and immunophenotypic characteristics, a diagnosis of TZL was confirmed, and conservative treatment was instituted with 2 mg of chlorambucil (4 mg/m² EOD, continuous use) and 20 mg of prednisolone (1 mg/kg SID for 7 days, then 0.5 mg/kg SID for 14 days, followed by 0.5 mg/kg SID every 48 hours for another 30 days). After diagnosis and treatment initiation, the dog returned for evaluation, and monitoring blood tests were performed (Table 2). In the first month of treatment, the animal presented with moderate anemia, with hematocrit values ranging from 26% to 27% in three tests. A single dose of oral lomustine was administered, at 60 mg/m2 in the second week but despite no adverse events, there was no improvement in the hematological parameters. The dog remained asymptomatic during the entire treatment and follow-up. Anemia became mild in the second month of treatment (hematocrit 35%), reaching normocytosis in the fourth month, with hematocrit 40%. Thereafter, the hematocrit oscillated near the lower limit of the reference range, being within the reference range in the last blood test (hematocrit 44%), performed after 15 months of follow-up. The anemia in the first and second months of treatment was accompanied by extreme leukocytosis of over 200,000 cells/µl, constituted by 88% to 99% lymphocytes with the same characteristics as the first blood test. In the fourth month of treatment, the erythroid normocytosis was accompanied by a decrease in leukocyte count to 89,000 cells/µl, still with 91% of lymphocytes. From the fifth month, leukocytosis became moderate and decreased until it reached a count of leukocytes within reference values (14,400 cells/µl) (Fig. 7A and B). In this test, lymphocytes represented 75% of leukocytes, with morphology similar to the first test. Pearson correlation test showed a strong negative correlation between hematocrit and leukocyte count (p=0.0009; rP=−0.851), and hematocrit and lymphocyte count (p=0.001; rP=−0.836).
Fig. 6. Flow cytometry immunophenotyping of blood sample (6.1), lymph node sample (6.2), and bone marrow sample (6.3) from a Golden Retriever with T-zone lymphoma. (A) Density plot of size (FSC) versus granularity (SSC) indicating the position of the lymphocyte population (delimited by the black line) for the analysis of the total T lymphocyte population and its CD4+ and CD8+ subpopulations. (B) Density plot of CD4-PE versus CD5-FITC used to quantify the percentage of total CD5+T lymphocytes (represented by the sum of frequencies Q1+Q2) and the CD5+CD4+ T lymphocyte subpopulation (Q2). (C) Density plot of CD8-PE versus CD5-FITC used to quantify the percentage of CD5+CD8+T lymphocyte subpopulation (Q2). (D) Density plot of CD45-Pacific Blue-A versus granularity (SSC) used to quantify the percentage of CD45+cells.
Fig. 7. Blood smear of 09/15/2022, Golden Retriever, T-zone lymphoma. (A) Red blood cell:white blood cell ratio of 462:1 (6,660,000 RBC/µl: 14,400 WBC/µl). Objective 10×. (B) After 11 months from the first blood test, lymphocytosis decreased from 152,048 cells/µl to 10,800 cells/µl, but the cells remained with a low nucleus:cytoplasm ratio. Objective 100×. Diff-Quik staining. In the ninth month of treatment, after clinical stabilization, a regional mastectomy was performed evolving the left inguinal, caudal abdominal, and cranial abdominal mammary glands. The histopathology was conclusive for malignant adenomyoepithelioma with no lymph node metastasis detected. To better understand the mammary neoplasm, immunohistochemistry was performed, which was positive for Ki-67 (5%), estrogen receptor (1%–25% [+]), and progesterone (75% [++++]), and negative for Cox-2. Imaging examinations were repeated and remained similar to the previous examination. After 11 months of treatment, with the maintenance of lymphocyte predominance in the leukogram (73% lymphocytes versus 27% neutrophils), the dose of chlorambucil was increased to 6 mg/m², every other day, for continuous use. In the hemogram performed 15 months after maintaining the treatment, a predominant count of neutrophils and lymphopenia without atypia was observed. At the time this paper was written, the dog had already survived for 577 days. DiscussionLymphoma is the most common hematopoietic neoplasm in dogs, representing 12% to 18% of all neoplasms in this species (Sayag et al., 2018). Canine lymphoma classification systems have been adapted from those used in humans and currently follow the World Health Organization (WHO) classification for neoplastic diseases of lymphoid tissues, where they are predominantly categorized as B and T cell lymphomas (Valli et al., 2011). T-cell lymphomas represent 30% to 40% of canine lymphomas and often present aggressive biological behavior, although they can also be characterized as indolent and exhibit different responses to treatment, depending on the subtype (Comazzi and Riondato, 2021). The TZL is the most common indolent lymphoma in dogs, accounting for up to 62% of indolent lymphomas and 29% of all canine lymphomas (Valli et al., 2006; Flood-Knapik et al., 2013). In humans, TZL is not a distinct classification but it is a rare variant within a category called not otherwise specified peripheral T-cell lymphomas, accounting for approximately 1.5% of cases within this group (Seelig et al., 2014). Due to its rarity in humans, it is not possible to compare the clinical course and treatment between the two species (Flood-Knapik et al., 2013). However, its high occurrence in dogs provides an excellent opportunity to study this disease, improving its understanding and treatment in both species. Canine TZL appears to be associated with genetic factors, as the Golden Retriever breed represented 41%, 44%, and 56% of cases in studies conducted in the United States (Seelig et al., 2014), Brazil (Lima, 2020), and Japan (Mizutani et al., 2016), respectively, while in Italy, it was not among the most affected breeds (Comazzi et al., 2018), possibly due to differences in lineages. A recent study identified a strong link between specific single nucleotide polymorphisms and TZL in Golden Retrievers. Significant associations were found in genome regions located on chromosomes 8 and 14 (Labadie et al., 2020). The average age of dogs affected by TZL ranges from eight to ten years (Valli et al., 2006; Seelig et al., 2014; Mizutani et al., 2016; Lima, 2020), which is similar to dogs with a general diagnosis of lymphoma (Mizutani et al., 2016). Therefore, the breed and age of the animal in this report follow the pattern of previous reports. Histologically, TZL is characterized as a diffuse proliferation of small to medium lymphocytes in the paracortical area (Kojima et al., 2022). Usually, cytology is the screening tool for lymphomas, as it is less invasive and has lower costs (Lima, 2020). In the case of TZL, the diagnosis can rarely be obtained on cytology, as the presence of a high concentration of small to medium cells with clear and elongated cytoplasm, can also indicate a reactive process in the paracortex region, which appears as a primary response preceding plasma cell proliferation, in cases of chronic dermatitis or in response to certain antigens, such as in cases of leishmaniasis or viral infections (Comazzi and Riondato, 2021). However, a TZL diagnosis can be suspected by the presence of a high concentration of small to medium cells with clear and elongated cytoplasm, resembling a “hand mirror” shape (Mizutani et al., 2016; Kojima et al., 2022). In addition to morphological analysis, samples collected by fine needle aspiration are amenable to flow cytometry immunophenotyping. In TZL, the phenotypic pattern is negative for the pan-leukocyte marker CD45 and positive for the T-cell markers CD3 and/or CD5 (Mizutani et al., 2016). Loss of expression of the CD45 marker is proposed as a confirmatory feature for TZL, allowing validation of the diagnosis even without observation of the histological architecture. Thus, cytological analysis associated with immunophenotyping can be diagnostic without the need for surgical procedures (Seelig et al., 2014). A possible limitation of this report is the absence of histopathological examination, although differentiation of TZL from other indolent lymphomas, may be difficult without immunophenotypic, cytogenetic, and/or molecular studies (Lima, 2020). CD45 is a tyrosine phosphatase protein used for the generalized identification of leukocytes. It is suggested that loss of expression of this surface marker, possibly due to the absence of transcription of its respective gene, allows the cell to evade thymic deletion or apoptotic signaling. This is because apoptosis induction is related to galectin binding to CD45 expressed on non-neoplastic cells (Martini et al., 2017). Loss of CD45 expression in other lymphomas is considered rare (Parachini-Winter et al., 2018; Stein et al., 2021), but highlights the importance of evaluating immunophenotyping together with clinical, morphological, and proliferation index data (Lima, 2020). Studies report loss of CD45 expression in over 95% of canine TZL cases (Martini et al, 2013; Seelig et al., 2014; Martini et al., 2015), which reinforces that this peculiar phenotypic characteristic, associated with typical cytological appearance and expansion of cells from the paracortex in histological sections, represents a unique entity (Martini et al., 2015). In the lymphocyte gate cells of the present case (Fig. 6), CD45- immunophenotype was observed in 69.7%, 71.8%, and 88.7% of peripheral blood, bone marrow, and lymph node samples, respectively. In a study, CD45-cells represented 30.8% to 98.0% of 40 TZL lymph nodes, with a median of 82.6% (Martini et al., 2017). Co-expression of CD4 and CD8 or absence of expression of both, have also been observed in 33% to 40% of TZL series (Seelig et al., 2014; Martini et al., 2015) as reported in the present case. The present report describes an extreme lymphocytosis in a dog with TZL. Lymphocytosis is a common finding in animals diagnosed with TZL and it is reported in 30% to 63% of cases (Flood-Knapik et al., 2013; Seelig et al., 2014; Mizutani et al., 2016; Lima, 2020); however, it is usually mild, with an average of 5,046 to 9,212 lymphocytes/μl (Flood-Knapik et al., 2013; Seelig et al., 2014; Martini et al., 2015). In the literature reviewed, the highest lymphocyte count reported in an animal diagnosed with TZL was 30,760 cells/μl (Martini et al., 2015), which is more than seven times lower than the lymphocytosis found in the case reported here. In this report, a differential examination of bone marrow cell types showed 22.8% lymphocytes, with lymphocyte gate immunophenotyping resulting in 71.8% CD45-. Martini et al. (2015) observed 0.5% to 24.1% in the bone marrow and 0.9% to 64.6% in peripheral blood using immunophenotyping as a criterion for the presence of neoplastic cells in the bone marrow and blood of dogs with TZL. In the first blood count of this report, the relative leukocyte count showed 95% lymphocytes, with 88.7% CD45- in immunophenotyping. These characteristics of bone marrow and peripheral blood are attributed to the release of nodal neoplastic cells directly into the peripheral blood instead of prior establishment in the bone marrow, which is known as the spillover. To differentiate lymphoproliferative disorders that present with neoplastic cells in peripheral blood, the origin of neoplasiais determined by the tissue that has the highest tumor volume, according to WHO classification (Comazzi et al., 2011). Leukemia is named when the neoplastic cell percentage is higher in the bone marrow and called lymphoma if the neoplasia is mainly in peripheral lymphoid organs. Thus, this case should be considered as stage V TZL due to bone marrow secondary involvement (Valli et al., 2013). In addition, the low degree of infiltration typically found in TZL cases also explains why this disorder is rarely associated with cytopenia (Flood-Knapik et al., 2013; Seelig et al., 2014; Martini et al., 2015), and can even present with thrombocytosis in 25% of cases (Mizutani et al., 2016). Nonregenerative anemia can occur in approximately 13% of cases probably due to anemia of chronic disease rather than BM infiltration (Mizutani et al., 2016). In this report instead, a myeloid:erythroid ratio of 2:3 was observed, close to the upper limit of the values of 0.8–2.5 reported by Jain (1993) and above the limits of 0.9–1.8 described by Harvey (2000), suggesting a decrease in BM production. Regardless of the reference used, the M:E ratio of 2:3 associated with 60% cellularity suggests a tendency to decrease erythroid lineage. Due to its indolent nature, the prognosis for dogs with TZL is considered favorable, with an estimated survival of 21 to 33 months (Flood-Knapik et al., 2013; Seelig et al., 2014; Martini et al., 2015), which is clearly much higher than the average survival of 5 months for not otherwise specified peripheral T-cell lymphoma in dogs (Valli et al. 2013). However, this survival expectation and the fact that TZL is considered the indolent form of canine lymphoma with a longer survival time (Valli et al., 2017) are not sufficient to predict the prognosis of the animal reported here, as there is no literature involving dogs with TZL associated with marked lymphocytosis and advanced staging (Stage V). In addition, although the increase in lymphocyte count in peripheral blood does not appear to correlate with survival time, the magnitude of lymphocytosis is related to lower survival rates in indolent lymphomas (Flood-Knapik et al., 2013). There is no consensus on the treatment of TZL, but the recommendation is for conservative use of chlorambucil and prednisone when the disorder is compromising the animal’s quality of life, through the manifestation of clinical signs or visceral involvement, and/or in cases of lymphocytosis above 30,000 cells/μl (de Lorimier and Campbell, 2020). Thus, extreme lymphocytosis and its persistence even after treatment may characterize a fair prognosis. However, in the last blood count, performed 15 months after diagnosis, the counts of red blood cells, white blood cells, and platelets were within reference values, and the animal’s physical examination showed no significant alterations. As an indolent form of lymphoma, usually associated with a low proliferation index (4), the progression of TZL is expectedly slow, and although the time to remission after initiation of chemotherapy is not reported for dogs with such disease it may take a few weeks, as observed in the present case even with intensification of the treatment with a maximum tolerated dose of lomustine. Once the dog was clinically well, it was decided to continue with the standard protocol based on chlorambucil and prednisolone. ConclusionIn conclusion, this work possibly describes the first case of extreme lymphocytosis in a dog with TTZL, highlighting the importance of cytological evaluation associated with flow cytometry immunophenotyping, even in cases considered unlikely according to the literature. The subclassification of lymphomas is extremely important for the treatment and prognosis, and the reporting of new characteristics related to specific subtypes is essential for a better understanding of the most common hematopoietic neoplasm in dogs. AcknowledgmentsNot applicable. Authors contributionsAll authors contributed to the writing of the article in their respective areas of expertise, reviewed, and agreed with the manuscript. PROP was responsible for the supervision and guidance of the work. BVS, RSH, and AG conducted oncological follow-up and clinical decision-making. BCM, MPC, FOPL, MMM, and PROP were responsible for clinical pathology and cytology. MMM, RMSM, RCG, and APS were responsible for conducting and interpreting flow cytometry. Conflict of interestThe authors declare that there is no conflict of interest. FundingThis work was supported by the Fundação de Amparo à Pesquisa do Estado de Minas Gerais (FAPEMIG) and Conselho Nacional para o Desenvolvimento Científico e Tecnológico (CNPq). Data availabilityAll the data that underpin the findings of this case report can be found in the manuscript. ReferencesComazzi, S., Gelain, M.E., Martini, V., Riondato, F., Miniscalco, B., Marconato, L., Stefanello, D. and Mortarino, M. 2011. Immunophenotype predicts survival time in dogs with chronic lymphocytic leukemia. J. Vet. Intern. Med. 25(1), 100–106. Comazzi, S., Marelli, S., Cozzi, M., Rizzi, R., Finotello, R., Henriques, J., Pastor, J., Ponce, F., Rohrer-Bley, C., Rütgen, B.C. and Teske, E. 2018. Breed-associated risks for developing canine lymphoma differ among countries: an European canine lymphoma network study. BMC Vet. Res. 14(1), 232. Comazzi, S. and Riondato, F. 2021. Flow Cytometry in the Diagnosis of Canine T-Cell Lymphoma. Front Vet Sci. 8, 600963. de Lorimier, L.P. and Campbell, O. 2020. Canine T-zone lymphoma: an apparent risk factor for adult-onset demodicosis. J. Small Anim. Pract. 61(5), 323–324. Flood-Knapik, K.E., Durham, A.C., Gregor, T.P., Sánchez, M.D., Durney, M.E. and Sorenmo, K.U. 2013. Clinical, histopathological and immunohistochemical characterization of canine indolent lymphoma. Vet. Comp. Oncol. 11(4), 272–286. Harvey, J.W. 2001. Bone marrow examination. In: Atlas of Veterinary Hematology: Blood and Bone Marrow of Domestic Animals, Eds., Harvey JW. 1st ed, Ed Saunders, Philadelphia, pp: 83-116. Jain, N.C. 1993. Essentials of veterinary hematology. Lea & Febiger, Philadelphia, pp: 417. Jark, P.C., Fracacio, C.P., Anai, L.A., Silva, M.C.L., Calazans, S.G., Senhorello, I.L.S., Costa, M.T., Sequeira, J.L. and Sueiro, F.A.R. 2020. Histopathological and immunophenotypical characterization of canine multicentric lymphoma in Brazil: a study of 203 cases. Arq. Bras. Med. Vet. Zootec. 72(3), 787–793. Kojima, K., Chambers, J.K., Mizuno, T. and Uchida, K. 2022. Nodal T-zone lymphoma and T-zone hyperplasia in dogs. Vet. Pathol. 59(5), 733–739. Labadie, J.D., Elvers, I., Feigelson, H.S., Magzamen, S., Yoshimoto, J., Dossey, J., Burnett, R. and Avery, A.C. 2020. Genome-wide association analysis of canine T zone lymphoma identifies link to hypothyroidism and a shared association with mast-cell tumors. BMC Genomics. 21(1), 464. Lima, G.M.C. 2020. Epidemiological and immunohistochemical characterization of multicentric indolent t-zone lymphoma in dogs, Dissertation, São Paulo, Jaboticabal, Brasil. Martini, V., Cozzi, M., Aricò, A., Dalla Rovere, G., Poggi, A., Albonico, F., Mortarino, M., Ciusani, E., Aresu, L. and Comazzi, S. 2017. Loss of CD45 cell surface expression in canine T-zone lymphoma results from reduced gene expression. Vet. Immunol. Immunopathol. 187, 14–19. Martini, V., Marconato, L., Poggi, A., Riondato, F., Aresu, L., Cozzi, M. and Comazzi, S. 2015. Canine small clear cell/T-zone lymphoma: clinical presentation and outcome in a retrospective case series. Vet. Comp. Oncol. 14, 117–126. Martini, V., Poggi, A., Riondato, F., Gelain, M.E., Aresu, L. and Comazzi, S. 2013. Flow-cytometric detection of phenotypic aberrancies in canine small clear cell lymphoma. Vet. Comp. Oncol. 13(3), 281–287. Mizutani, N., Goto-Koshino, Y., Takahashi, M., Uchida, K. and Tsujimoto, H. 2016. Clinical and histopathological evaluation of 16 dogs with T-zone lymphoma. J. Vet. Med. Sci. 78(8), 1237–1244. Parachini-Winter, C., Curran, K.M., Russell, D.S. and Gorman, E. 2018. A case of canine high-grade T-cell lymphoma immunophenotypically consistent with T-zone lymphoma. Vet. Clin. Pathol. 47, 643–648. Sayag, D., Fournel-Fleury, C. and Ponce, F. 2018. Prognostic significance of morphotypes in canine lymphomas: a systematic review of literature. Vet. Comp. Oncol. 16(1), 12–19. Seelig, D.M., Avery, P., Webb, T., Yoshimoto, J., Bromberek, J., Ehrhart, E.J. and Avery, A.C. 2014. Canine T-zone lymphoma: unique immunophenotypic features, outcome, and population characteristics. J. Vet. Intern. Med. 28(3), 878–886. Stein, L., Bacmeister, C. and Kiupel, M. 2021. Immunophenotypic characterization of canine nodal T-Zone lymphoma. Vet. Pathol. 58(2), 288–292. Valli, V.E., Bienzle, D. and Meuten, D.J. 2017. Tumors of the hemolymphatic system. In: Tumors in Domestic Animals, Eds., Meuten D.J. Wiley Blackwell, pp: 203–321. Valli, V.E., Kass, P.H., San Myint, M. and Scott, F. 2013. Canine lymphomas: association of classification type, disease stage, tumor subtype, mitotic rate, and treatment with survival. Vet. Pathol. 50(5), 738–748. Valli, V.E., San Myint, M., Barthel, A., Bienzle, D., Caswell, J., Colbatzky, F., Durham, A., Ehrhart, E.J., Johnson, Y., Jones, C., Kiupel, M., Labelle, P., Lester, S., Miller, M., Moore, P., Moroff, S., Roccabianca, P., Ramos-Vara, J., Ross, A., Scase, T., Tvedten, H. and Vernau, W. 2011. Classification of canine malignant lymphomas according to the World Health Organization criteria. Vet. Pathol. 48(1), 198–211. Valli, V.E., Vernau, W., de Lorimier, L.P., Graham, O.S. and Moore, P.F. 2006. Canine indolent nodular lymphoma. Vet. Pathol. 43(3), 241–256. | ||
| How to Cite this Article |
| Pubmed Style Sena BVD, Mello BCD, Horta RDS, Costa MDP, Melo MM, Mariano RMDS, Giunchetti RC, Giuliano A, Leme FDOP, Sabino ADP, Paes PRDO. Extreme lymphocytosis in a dog with T-zone lymphoma. Open Vet. J.. 2023; 13(12): 1760-1768. doi:10.5455/OVJ.2023.v13.i12.25 Web Style Sena BVD, Mello BCD, Horta RDS, Costa MDP, Melo MM, Mariano RMDS, Giunchetti RC, Giuliano A, Leme FDOP, Sabino ADP, Paes PRDO. Extreme lymphocytosis in a dog with T-zone lymphoma. https://www.openveterinaryjournal.com/?mno=154118 [Access: January 25, 2026]. doi:10.5455/OVJ.2023.v13.i12.25 AMA (American Medical Association) Style Sena BVD, Mello BCD, Horta RDS, Costa MDP, Melo MM, Mariano RMDS, Giunchetti RC, Giuliano A, Leme FDOP, Sabino ADP, Paes PRDO. Extreme lymphocytosis in a dog with T-zone lymphoma. Open Vet. J.. 2023; 13(12): 1760-1768. doi:10.5455/OVJ.2023.v13.i12.25 Vancouver/ICMJE Style Sena BVD, Mello BCD, Horta RDS, Costa MDP, Melo MM, Mariano RMDS, Giunchetti RC, Giuliano A, Leme FDOP, Sabino ADP, Paes PRDO. Extreme lymphocytosis in a dog with T-zone lymphoma. Open Vet. J.. (2023), [cited January 25, 2026]; 13(12): 1760-1768. doi:10.5455/OVJ.2023.v13.i12.25 Harvard Style Sena, B. V. D., Mello, . B. C. D., Horta, . R. D. S., Costa, . M. D. P., Melo, . M. M., Mariano, . R. M. D. S., Giunchetti, . R. C., Giuliano, . A., Leme, . F. D. O. P., Sabino, . A. D. P. & Paes, . P. R. D. O. (2023) Extreme lymphocytosis in a dog with T-zone lymphoma. Open Vet. J., 13 (12), 1760-1768. doi:10.5455/OVJ.2023.v13.i12.25 Turabian Style Sena, Bruna Voltolin De, Bárbara Correa De Mello, Rodrigo Dos Santos Horta, Mariana De Pádua Costa, Marilia Martins Melo, Reysla Maria Da Silveira Mariano, Rodolfo Cordeiro Giunchetti, Antonio Giuliano, Fabiola De Oliveira Paes Leme, Adriano De Paula Sabino, and Paulo Ricardo De Oliveira Paes. 2023. Extreme lymphocytosis in a dog with T-zone lymphoma. Open Veterinary Journal, 13 (12), 1760-1768. doi:10.5455/OVJ.2023.v13.i12.25 Chicago Style Sena, Bruna Voltolin De, Bárbara Correa De Mello, Rodrigo Dos Santos Horta, Mariana De Pádua Costa, Marilia Martins Melo, Reysla Maria Da Silveira Mariano, Rodolfo Cordeiro Giunchetti, Antonio Giuliano, Fabiola De Oliveira Paes Leme, Adriano De Paula Sabino, and Paulo Ricardo De Oliveira Paes. "Extreme lymphocytosis in a dog with T-zone lymphoma." Open Veterinary Journal 13 (2023), 1760-1768. doi:10.5455/OVJ.2023.v13.i12.25 MLA (The Modern Language Association) Style Sena, Bruna Voltolin De, Bárbara Correa De Mello, Rodrigo Dos Santos Horta, Mariana De Pádua Costa, Marilia Martins Melo, Reysla Maria Da Silveira Mariano, Rodolfo Cordeiro Giunchetti, Antonio Giuliano, Fabiola De Oliveira Paes Leme, Adriano De Paula Sabino, and Paulo Ricardo De Oliveira Paes. "Extreme lymphocytosis in a dog with T-zone lymphoma." Open Veterinary Journal 13.12 (2023), 1760-1768. Print. doi:10.5455/OVJ.2023.v13.i12.25 APA (American Psychological Association) Style Sena, B. V. D., Mello, . B. C. D., Horta, . R. D. S., Costa, . M. D. P., Melo, . M. M., Mariano, . R. M. D. S., Giunchetti, . R. C., Giuliano, . A., Leme, . F. D. O. P., Sabino, . A. D. P. & Paes, . P. R. D. O. (2023) Extreme lymphocytosis in a dog with T-zone lymphoma. Open Veterinary Journal, 13 (12), 1760-1768. doi:10.5455/OVJ.2023.v13.i12.25 |